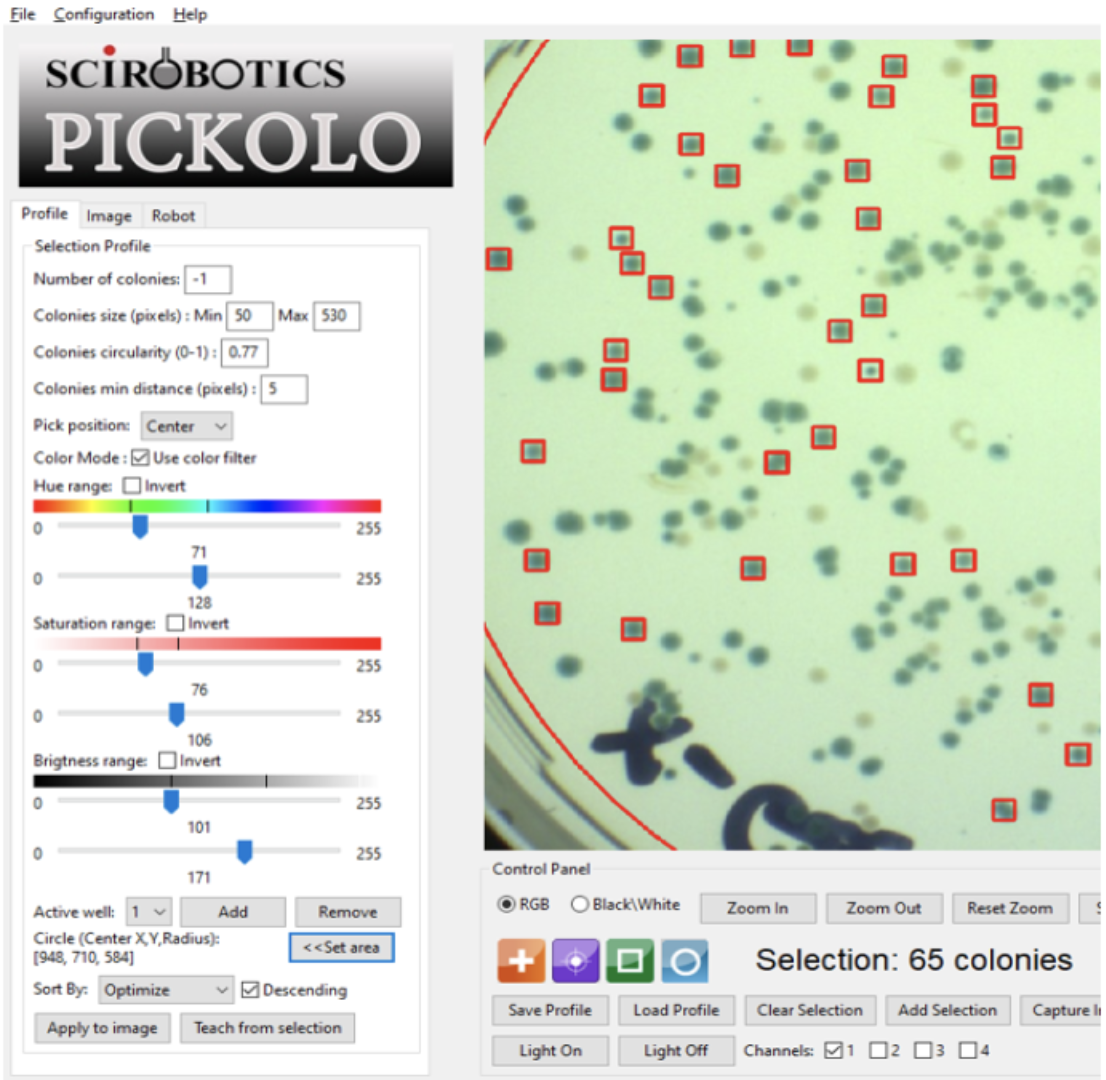
pickoloprogram.png

lims-guide-viewing-data
Media Manager
Media Files
Files in [root]

- 02_pavone.png
- 1269×995
- 2024/12/12 00:41
- 456.5 KB
- 96-wellexperiment.pdf
- 2021/08/24 18:41
- 3.7 MB
- 96_well_plate_layout.pdf
- 2021/08/24 18:23
- 379.5 KB
- 440140_-_azenta_xpeel_user_manual.pdf
- 2024/10/08 19:40
- 11.4 MB
- 30124664_ifu_spark_ref_english_v2_0.pdf
- 2024/10/08 19:40
- 11.1 MB
- aapptec_synthesis_guide.pdf
- 2024/11/25 21:01
- 794 KB

- accept-invite.png
- 330×169
- 2025/07/29 01:15
- 21.6 KB

- access_and_training_requirements_for_bpm_092022.jpg
- 999×186
- 2024/09/05 01:53
- 48.8 KB

- add-advisor.png
- 440×293
- 2025/07/29 21:20
- 29.3 KB

- advisor-step-down-request.png
- 374×258
- 2025/07/29 22:18
- 30.1 KB

- advisor-step-down.png
- 400×167
- 2025/07/29 22:18
- 15 KB

- ai_agent_response.png
- 600×872
- 2025/06/11 19:44
- 145.5 KB

- ai_agent_response_2.png
- 600×872
- 2025/06/11 19:44
- 136.5 KB
- amp_led_uv-cube_ii.pdf
- 2022/05/27 21:51
- 802.8 KB

- analytical_hplc.jpg
- 640×480
- 2024/10/16 19:48
- 53 KB
- analytical_hplc_manual.pdf
- 2024/10/16 19:55
- 26.8 MB

- annotations_expanded.png
- 1638×82
- 2025/04/09 20:31
- 16.7 KB

- annotations_plate_added_expanded.png
- 1638×911
- 2025/04/09 19:08
- 278.6 KB

- annotations_plate_head.png
- 1638×288
- 2025/04/09 19:07
- 55.9 KB

- axium720cameraspecs-01.jpg
- 1978×1319
- 2021/08/04 04:37
- 217.7 KB

- biology_annotations.png
- 1304×1118
- 2025/01/22 17:12
- 111.4 KB

- biopacific_mipbiox.png
- 1166×1166
- 2021/06/16 17:30
- 708.3 KB

- bioshake.png
- 1746×1506
- 2024/10/18 21:27
- 1.9 MB
- bioshakeoperatingmanual.pdf
- 2024/10/18 22:18
- 1.6 MB
- bioshakeproductsheet.pdf
- 2024/10/18 22:18
- 1.6 MB

- biotageseleck.png
- 1424×1456
- 2022/02/15 16:42
- 1.8 MB

- biotagev10touch.jpg
- 1424×1492
- 2022/02/11 19:48
- 665 KB
- biotagev10touchmanual.pdf
- 2022/02/11 19:48
- 6.1 MB
- biotage_flash_cartridge_user_guide.pdf
- 2022/02/16 17:15
- 1.7 MB
- biotage_selekt_user_manual.pdf
- 2022/02/15 16:42
- 10.2 MB
- biox_manual.pdf
- 2021/06/15 20:53
- 4.8 MB
- biox_temperature-control-3.3.pdf
- 2021/06/16 18:06
- 2.3 MB

- bio_plate_and_individ_well.png
- 1031×827
- 2025/04/07 18:09
- 143 KB

- bio_plate_annotation_start.png
- 411×204
- 2025/04/08 21:43
- 22.8 KB

- bio_plate_step_two.png
- 570×734
- 2025/04/08 21:51
- 65.6 KB

- bpm-lims-data-relationships-wiki.png
- 1608×1314
- 2023/04/07 18:40
- 295.2 KB

- bpm-lims-dataviewer-view-wiki.png
- 1128×535
- 2023/04/07 18:07
- 78.8 KB

- bpm-lims-home-view-wiki.png
- 1251×581
- 2023/04/07 17:59
- 368.6 KB

- bpm-lims-wiki.png
- 1140×679
- 2023/04/06 21:23
- 140.3 KB

- bpm-meta-batch-wiki-2.png
- 738×288
- 2023/04/07 17:43
- 41.7 KB

- bpm-meta-batch-wiki.png
- 750×295
- 2023/04/07 17:14
- 41.7 KB

- bpm-meta-form-wiki.png
- 741×507
- 2023/04/07 17:13
- 85.1 KB

- bpm_portal_2025.png
- 1318×799
- 2025/01/20 18:56
- 243.7 KB

- btxelec.jpg
- 650×478
- 2024/10/08 20:11
- 42.8 KB

- carbon3dm2.jpg
- 332×625
- 2022/05/27 21:26
- 77.4 KB
- carbonresinguide.pdf
- 2022/05/27 21:20
- 119.7 KB

- chemistry_annotations.png
- 1304×428
- 2025/01/22 16:58
- 59.5 KB

- chemspeed.png
- 1866×696
- 2024/10/11 19:49
- 2 MB

- chemspeed_exp_reg_2026.png
- 407×340
- 2026/01/27 17:36
- 36.4 KB

- chemspeed_stocks_table_2026.png
- 1345×514
- 2026/01/27 17:44
- 88.5 KB

- chemspeed_stock_search_2026.png
- 1632×861
- 2026/01/27 17:38
- 123.6 KB

- chemspeed_stock_search_add_new_2026.png
- 262×582
- 2026/01/27 17:39
- 27.4 KB

- chemspeed_stock_search_add_pubchem_2026.png
- 262×667
- 2026/01/27 17:41
- 33.7 KB

- chem_plate_annotation_start.png
- 413×169
- 2025/04/08 21:29
- 18.3 KB

- chem_plate_step_four.png
- 1636×1267
- 2025/04/09 17:47
- 204.7 KB

- chem_plate_step_three.png
- 1636×619
- 2025/04/09 17:30
- 84.7 KB

- chem_plate_step_two.png
- 1636×409
- 2025/04/08 22:08
- 54.3 KB

- cnsi_tc_safety_training_requirements_2.jpg
- 354×260
- 2024/09/05 02:43
- 25.8 KB

- cnsi_tc_safety_training_requirements_3.jpg
- 832×243
- 2024/09/05 02:47
- 40.5 KB

- cnsi_tc_safety_training_requirements_4.jpg
- 808×240
- 2024/09/05 02:48
- 36.7 KB

- cnsi_tc_safety_training_requirements_5.jpg
- 232×170
- 2024/09/05 02:50
- 9 KB

- cnsi_tc_safety_training_requirements_67_.jpg
- 380×152
- 2024/09/05 02:38
- 12.8 KB

- combi.png
- 816×472
- 2024/11/23 00:20
- 328.3 KB

- create-group.png
- 413×250
- 2025/07/29 01:04
- 19.2 KB
- creationworkshop.pdf
- 2021/06/15 20:53
- 1.6 MB

- desktopsetup.png
- 4180×2918
- 2024/03/05 01:52
- 3 MB

- digital_ecosystem_diagram_2026.png
- 990×595
- 2026/01/27 18:30
- 165 KB
- dry_loading_vessels.pdf
- 2022/02/16 17:15
- 73.8 KB

- edit-group.png
- 350×376
- 2025/07/29 01:09
- 28.2 KB

- eln_categories_menu.png
- 782×529
- 2024/03/04 22:59
- 21.9 KB

- eln_chemical_tables.png
- 896×772
- 2024/03/05 16:58
- 59.8 KB

- eln_commands_menu.png
- 782×529
- 2024/03/04 22:59
- 26.4 KB

- eln_dev_page.png
- 1309×1142
- 2024/03/04 20:12
- 202.8 KB

- eln_editor.png
- 1302×1270
- 2024/03/04 20:12
- 240.9 KB

- eln_editor_shortcuts.png
- 405×456
- 2024/03/04 22:51
- 47.1 KB

- eln_emojis_menu.png
- 782×529
- 2024/03/04 22:59
- 22.6 KB

- eln_home.png
- 1309×891
- 2024/03/04 20:12
- 210.8 KB

- eln_lims_data_flow_fixed.png
- 449×186
- 2024/03/05 18:16
- 38 KB

- eln_mechanisms_menu.png
- 782×529
- 2024/03/04 22:59
- 25.7 KB

- eln_navigation-notebook.png
- 1309×72
- 2024/03/04 20:35
- 13.4 KB

- eln_notebook_page.png
- 1307×1274
- 2024/03/04 20:40
- 82.4 KB

- elx405.png
- 750×618
- 2024/11/25 07:31
- 392.3 KB
- elx405cleaning.pdf
- 2024/11/25 07:30
- 104 KB
- elx405manual.pdf
- 2024/11/25 07:30
- 1.8 MB
- elx405_user_manual_sd-xb000358.pdf
- 2024/10/08 19:40
- 5.3 MB
- emdmanual-3.2.pdf
- 2021/06/16 18:06
- 3.4 MB
- ez2manual.pdf
- 2024/10/21 18:20
- 4.4 MB
- fbs_-_iw_and_ufl_reservations.pdf
- 2020/11/20 17:58
- 741.7 KB
- fbs_-_workshop_wizard_time_reporting.pdf
- 2020/10/18 23:55
- 261.9 KB

- file_attachment_attaching.png
- 1304×118
- 2025/01/22 18:16
- 14.5 KB

- file_attachment_display.png
- 1304×530
- 2025/01/22 18:14
- 98 KB

- file_attachment_example_spectra.png
- 425×571
- 2025/01/22 18:22
- 33.2 KB

- file_upload_display.png
- 1396×371
- 2026/01/26 18:00
- 79.5 KB

- file_upload_initial_2026.png
- 450×362
- 2026/01/26 18:03
- 26.6 KB

- flowsystem.jpg
- 4032×3024
- 2024/10/16 20:07
- 11.7 MB

- fluent.png
- 1262×1234
- 2024/10/18 21:19
- 1.6 MB

- fluentcontrol.png
- 1314×1040
- 2024/10/18 23:23
- 505.9 KB
- fluentcontrolbrochure.pdf
- 2024/10/18 23:29
- 4.8 MB
- fluentcontrol_3.6_manual.pdf
- 2024/10/18 23:29
- 68.1 MB
- fluentliquidhandler-guide.pdf
- 2024/10/18 21:16
- 2 MB

- fluentliquidhandler.jpg
- 1000×665
- 2024/10/17 23:16
- 188.4 KB
- fluentoperatingmanual.pdf
- 2024/10/18 21:19
- 109 MB
- fluentreferencemanual.pdf
- 2024/10/18 21:19
- 14.6 MB

- fluorescent_cubes.jpg
- 1487×563
- 2021/07/23 19:33
- 152.3 KB
- freeze_dryer_manual.pdf
- 2024/10/15 00:17
- 3.4 MB

- full_eln_view.png
- 2304×2156
- 2025/01/21 19:29
- 800.2 KB

- genevac.jpg
- 3024×4032
- 2024/10/14 21:33
- 914.8 KB

- gfpickolo.png
- 2762×874
- 2024/10/19 02:54
- 3.1 MB

- gfpickolo2.png
- 2762×874
- 2024/10/19 02:55
- 3.1 MB
- gradient_mnwr-s01-job_file_structure.pdf
- 2022/08/24 21:43
- 388.5 KB

- group-notebooks-tree-page.png
- 1693×862
- 2025/07/29 22:34
- 229.3 KB

- gui.png
- 498×162
- 2024/03/05 01:57
- 39.1 KB
- hplcmanualshimadzunexera.pdf
- 2021/10/29 23:49
- 30.7 MB

- image.jpg
- 1280×720
- 2024/10/02 17:18
- 30.4 KB

- img_2856.jpeg
- 4032×3024
- 2024/10/14 01:58
- 2.3 MB

- img_4965.jpg
- 4032×3024
- 2024/10/15 17:21
- 1.1 MB

- individ_well_only.png
- 287×466
- 2025/04/07 19:52
- 39.2 KB

- individ_well_only_expanded.png
- 547×466
- 2025/04/07 19:52
- 56.2 KB

- information_for_visiting_biopacific_mip_at_ucsb_122024.jpg
- 1696×2195
- 2025/02/07 22:57
- 580.3 KB

- introbiopacificmip.png
- 578×219
- 2023/04/03 21:47
- 50.8 KB

- introbiopacificmip_no_background_alternative.png
- 578×219
- 2024/10/10 20:55
- 43.6 KB

- labconco.jpg
- 640×480
- 2024/10/14 22:51
- 48.4 KB

- lbf.jpg
- 535×301
- 2024/09/27 21:21
- 37.7 KB

- ledintensity.png
- 937×556
- 2025/10/22 18:24
- 93.9 KB

- led_control.png
- 507×237
- 2024/10/11 17:28
- 44.9 KB

- library_add_2026.png
- 609×339
- 2026/01/27 21:57
- 37.1 KB

- library_dashboard_2026.png
- 854×557
- 2026/01/27 21:50
- 51.6 KB

- library_display_2026.png
- 1307×863
- 2026/01/27 21:42
- 198.3 KB

- library_edit_2026.png
- 512×1073
- 2026/01/27 22:00
- 108.9 KB

- library_filter_results_2026.png
- 1605×1389
- 2026/01/27 21:44
- 314.2 KB

- library_home_2026.png
- 1144×584
- 2026/01/27 21:26
- 531.3 KB

- lightvspower-01.jpg
- 1638×1207
- 2021/09/30 20:50
- 109.4 KB
- lightvspower.pdf
- 2021/09/30 20:49
- 74 KB

- lims_data.png
- 875×618
- 2024/03/04 19:02
- 207.4 KB

- lims_dataviewer_file.png
- 1309×1176
- 2024/03/05 17:46
- 202.1 KB

- lims_dataviewer_search.png
- 1309×1176
- 2024/03/05 17:45
- 131 KB

- lims_home.png
- 1308×979
- 2024/03/04 18:48
- 562.2 KB

- lims_home_dataviewer.png
- 1308×979
- 2024/03/05 18:26
- 515.1 KB

- lims_importwizard_batchdefine.png
- 1309×433
- 2024/03/05 18:48
- 81.5 KB

- lims_importwizard_notebookpages.png
- 1309×920
- 2024/03/05 18:39
- 130.7 KB

- lims_importwizard_plateimport.png
- 1309×708
- 2024/03/05 18:37
- 109.9 KB

- lims_importwizard_start.png
- 1309×529
- 2024/03/05 18:34
- 80.3 KB

- lims_importwizard_upload.png
- 1308×1315
- 2024/03/05 18:48
- 156 KB

- lims_importwizard_wellplateassignments.png
- 1309×920
- 2024/03/05 18:44
- 146.6 KB

- lims_importwizard_wellplateqrcode.png
- 1309×776
- 2024/03/05 18:44
- 111.9 KB

- lims_menu_import.png
- 797×310
- 2024/03/04 19:30
- 53.1 KB

- logo.png
- 8726×5674
- 2025/09/18 23:00
- 1.8 MB

- lum296ls365.jpg
- 600×600
- 2024/10/10 03:16
- 60.2 KB
- lumenx.pdf
- 2021/07/02 18:53
- 922.2 KB

- lumenxphoto.jpg
- 738×990
- 2021/06/16 16:32
- 199.1 KB
- lumidox-ii-manual_rev1h.pdf
- 2024/03/05 01:31
- 2.3 MB

- lumidox_420nm_power.png
- 2772×1666
- 2024/10/11 17:11
- 1.1 MB

- maps_eval_2026.png
- 1847×705
- 2026/02/03 17:34
- 144.6 KB

- metadata-success-batch.png
- 657×93
- 2023/04/10 22:58
- 7.6 KB

- metadata-success.png
- 657×136
- 2023/04/10 18:56
- 18.4 KB

- metdata-batch-unzipped.png
- 878×760
- 2023/04/10 23:09
- 115.1 KB

- microfluidics-lab.jpg
- 820×479
- 2016/12/13 18:23
- 195.7 KB

- microscopeobjectives.jpg
- 1418×1019
- 2021/07/26 18:02
- 263.2 KB
- mn3z-c01a-mono3z2_assembly.pdf
- 2022/08/24 21:43
- 3.2 MB
- mn3z-c01c-mono3z4_assembly.pdf
- 2022/08/24 21:43
- 5.7 MB
- mn3z-c02-mono3z_printer_firmware.pdf
- 2022/08/24 21:43
- 1.4 MB
- mn3z-c03-job_file_preparation.pdf
- 2022/08/24 21:43
- 698.6 KB
- mn3z-c04-mono3z_first_printing.pdf
- 2022/08/24 21:43
- 893.3 KB
- mn3z-c05-mono3z2_led_swapping.pdf
- 2022/08/24 21:43
- 2.2 MB
- mn3z-c08-mono3z4_4ch_printing.pdf
- 2022/08/24 21:43
- 816.2 KB
- mn3z-c12-mono3z2_wiper_heater.pdf
- 2022/08/24 21:43
- 2.6 MB
- mnwr-s01-job_file_structure_copy.pdf
- 2022/08/24 21:43
- 388.5 KB
- mnwr-s03-power_measurement.pdf
- 2022/08/24 21:43
- 775.8 KB
- momentum_6.1_training_module_4_v3_spinnaker_advanced.pdf
- 2024/10/08 19:40
- 2.6 MB

- mono1.jpg
- 522×760
- 2021/06/16 22:09
- 658.9 KB

- mono1_rgb_leds-01.jpg
- 2028×1391
- 2021/12/13 20:48
- 371.5 KB

- mono3jpg.jpg
- 1163×1312
- 2021/06/16 19:14
- 328.7 KB
- mono3manual.pdf
- 2021/06/16 19:33
- 2.3 MB

- mono3mz4.png
- 724×965
- 2025/10/22 18:17
- 156.1 KB

- mono3z2_.png
- 1412×1542
- 2022/08/24 21:36
- 1.4 MB
- multidropcombimanual.pdf
- 2024/11/23 00:50
- 8.9 MB
- multidrop_combi.pdf
- 2024/11/23 00:50
- 2.3 MB
- multiwellplatecalibration.pdf
- 2021/08/24 18:41
- 4.3 MB

- notebook_first_view.png
- 1349×421
- 2025/01/21 22:34
- 49.4 KB

- nsf-biopacific-mip-logo-dmr-2445868.png
- 8726×5674
- 2025/09/18 22:26
- 3.3 MB
- operating_instructions_cytomat_44.pdf
- 2024/10/08 19:40
- 3.9 MB

- page_annotations.png
- 1094×82
- 2025/01/22 00:08
- 7.5 KB

- page_header_only.png
- 1056×93
- 2025/04/09 21:53
- 22.2 KB
- pavone_manual_v1_6.2.pdf
- 2024/12/12 00:54
- 5.4 MB
- penumatic-3.1.pdf
- 2021/06/16 18:06
- 1.9 MB

- pickolo.png
- 642×660
- 2024/10/18 23:08
- 596 KB

- pickoloimage.png
- 2728×1356
- 2024/10/18 23:12
- 3.9 MB
- pickoloprogram.png
- 1106×1080
- 2024/10/18 23:10
- 1.1 MB

- plate_annotations.png
- 1304×1506
- 2025/01/22 17:39
- 298.9 KB

- portal_2026.png
- 1846×1193
- 2026/01/27 20:55
- 1.4 MB

- portal_home.png
- 1308×1279
- 2024/03/05 17:19
- 1.4 MB

- portal_relationships.png
- 769×475
- 2024/03/05 17:27
- 72.8 KB

- pos-1-38hegfp.jpg
- 1230×684
- 2021/07/26 20:33
- 182.5 KB

- pos-2-43hedsred.jpg
- 1234×684
- 2021/07/26 20:33
- 206.1 KB

- pos-3-50cy5.jpg
- 1231×684
- 2021/07/26 20:34
- 205.6 KB

- pos-4-90he_d_g_c3.jpg
- 1232×720
- 2021/07/26 20:34
- 283.5 KB

- pos-5-96hebfp.jpg
- 1229×684
- 2021/07/26 20:34
- 172.1 KB

- powerled.png
- 1450×1240
- 2022/08/24 21:40
- 160 KB

- powerspectrum_leds.png
- 1546×970
- 2022/08/24 21:41
- 145.2 KB

- preludex.jpg
- 3024×2438
- 2024/10/14 21:01
- 834.4 KB
- prelude_x_user_manual.pdf
- 2024/10/14 21:05
- 5.1 MB

- prep_hplc.jpg
- 640×499
- 2024/10/16 19:48
- 56.6 KB
- prep_hplc_manual.pdf
- 2024/10/16 19:55
- 39.7 MB

- printheads-01.jpg
- 827×704
- 2021/06/16 18:54
- 153.6 KB

- publish_modal.png
- 440×332
- 2025/04/09 21:55
- 39.3 KB

- publish_selected_notebooks.png
- 424×361
- 2025/04/09 22:36
- 31.3 KB

- publish_start.png
- 889×669
- 2025/04/09 22:35
- 133.7 KB
- removing_and_cleaning_ion_transfer_tube.pdf
- 2024/11/01 17:58
- 2 MB

- research-groups.png
- 1341×471
- 2025/07/29 01:02
- 94.2 KB

- retract_modal.png
- 440×332
- 2025/04/09 21:55
- 38.8 KB

- saxs_gui1.png
- 2791×1517
- 2024/10/14 02:56
- 1.5 MB

- saxs_gui2.png
- 2795×1526
- 2024/10/14 03:08
- 1.6 MB

- saxs_gui3.png
- 2809×1521
- 2024/10/14 03:21
- 1.5 MB

- saxs_gui4.png
- 2809×1530
- 2024/10/14 03:28
- 1.6 MB

- saxs_gui4gi.png
- 2809×1521
- 2024/10/14 03:37
- 1.6 MB

- saxs_gui4temp.png
- 2809×1521
- 2024/10/14 03:39
- 1.6 MB

- saxs_hutch.png
- 1860×2209
- 2024/10/14 02:48
- 5.5 MB

- saxs_loadsample.jpg
- 405×405
- 2024/10/14 02:38
- 52.9 KB

- saxs_loadsample.png
- 1860×1860
- 2024/10/14 02:41
- 4.8 MB

- screenshot_2025-01-21_at_08.30.27.png
- 307×383
- 2025/01/21 16:30
- 39.2 KB

- screenshot_2025-01-21_at_14.15.32.png
- 1814×668
- 2025/01/21 22:16
- 122.4 KB

- screenshot_2025-01-21_at_14.53.08.png
- 2006×834
- 2025/01/21 22:53
- 391.8 KB

- screenshot_2025-01-21_at_15.02.59.png
- 1270×887
- 2025/01/21 23:03
- 179.7 KB
- sds_hcl.pdf
- 2021/06/18 17:39
- 184.1 KB
- sds_naoh.pdf
- 2021/06/18 17:39
- 121.7 KB

- select-notebook-visibility.png
- 518×316
- 2025/07/29 22:22
- 37.4 KB

- send-invite.png
- 400×250
- 2025/07/29 01:11
- 20.4 KB

- share_snapshot.png
- 528×345
- 2025/01/21 23:21
- 29.2 KB

- shimadzunexerahplc.png
- 1828×1374
- 2021/10/29 23:31
- 3.8 MB

- single_plate.png
- 250×556
- 2025/01/22 21:01
- 61.1 KB

- smallprinterschematic.jpg
- 827×827
- 2021/06/15 20:53
- 209.1 KB

- small_powerspectrum-01.jpg
- 2026×1161
- 2021/12/13 21:25
- 211.1 KB
- small_projector_manual.pdf
- 2021/06/15 20:53
- 2.1 MB
- sop_hydrochloric_acid_2436.pdf
- 2021/06/18 17:39
- 186.3 KB
- sop_sodium_hydroxide_2436.pdf
- 2021/06/18 17:39
- 181.8 KB

- spectrum.png
- 5000×3000
- 2024/03/05 01:24
- 197.4 KB
- spinnaker_user_guide.pdf
- 2024/10/08 19:40
- 1.5 MB
- submonomer_synthesis.pdf
- 2024/11/25 21:04
- 1 MB

- symphonyx.jpg
- 3024×4032
- 2024/10/14 20:55
- 1.6 MB

- symphony_annotation_module_2026.png
- 1445×543
- 2026/01/27 02:04
- 123.3 KB

- symphony_attached_annotations_2026.png
- 1441×502
- 2026/01/27 02:04
- 165.9 KB

- symphony_attached_file_contents_2026.png
- 1441×503
- 2026/01/27 02:04
- 96.5 KB
- symphony_uickstartguide.pdf
- 2024/10/14 21:15
- 115.2 KB
- symphony_x_quick_start_guide_updated_062821.docx
- 2021/06/29 01:20
- 186.3 KB
- sympohony_user_manual.pdf
- 2024/10/14 21:15
- 4.6 MB
- syringe-3.3.pdf
- 2021/06/16 18:06
- 1.8 MB
- ta_manual.pdf
- 2021/06/22 19:10
- 170.5 MB

- tecanhydrospeed.png
- 980×666
- 2024/10/18 22:18
- 258.4 KB
- tecanhydrospeed_user_manual.pdf
- 2024/10/18 22:33
- 986.2 KB

- tem_grids.jpg
- 1430×626
- 2024/10/02 20:34
- 190.2 KB

- tevacs.png
- 1260×1128
- 2024/10/18 22:42
- 1.3 MB
- tevacscleaningprotocol.pdf
- 2024/11/23 00:01
- 301.3 KB
- tevacsoperatingmanual.pdf
- 2024/10/18 22:42
- 3.6 MB

- textureanalyzer.jpg
- 1110×1200
- 2021/10/28 16:21
- 53.7 KB
- textureanalyzer.pdf
- 2021/10/28 16:44
- 170.5 MB

- textureanalyzer.png
- 1318×1428
- 2021/06/22 19:09
- 757 KB
- thermoplastic-3.0.pdf
- 2021/06/16 18:06
- 1.9 MB

- toolheads.png
- 945×308
- 2024/10/11 19:56
- 200.5 KB
- trainingmaterial.pptx
- 2024/10/08 21:12
- 75.6 MB
- trainingmaterial_cm7-2-10_qqq_sm_1_.pptx
- 2024/10/08 21:11
- 75.6 MB

- transfer_ownership.png
- 868×357
- 2025/04/09 22:42
- 54.7 KB

- transfer_ownership_2026.png
- 786×272
- 2026/01/26 21:34
- 47 KB

- transfer_ownership_full_2026.png
- 783×385
- 2026/01/26 21:37
- 55.6 KB

- transfer_ownership_partial_2026.png
- 780×563
- 2026/01/26 21:37
- 75.1 KB

- triple_quad.jpg
- 1026×779
- 2024/10/08 21:19
- 83.9 KB
- tsq_hardware_manual.pdf
- 2024/10/08 21:11
- 14.6 MB

- uvcuringoven.png
- 1060×1378
- 2022/05/27 21:53
- 821.8 KB

- uvplate.png
- 599×595
- 2024/03/05 00:37
- 295.9 KB

- vial2.png
- 656×987
- 2024/10/02 21:14
- 21.1 KB

- view-cancel-invite.png
- 409×185
- 2025/07/29 01:15
- 20.6 KB

- view-groups.png
- 732×536
- 2025/07/29 01:07
- 63.2 KB

- workflow_diagram_planning_whiteboard_in_green_yellow_modern_professional_style_1_.png
- 772×569
- 2024/10/02 21:33
- 86.6 KB

- ws_650_23npp_spin_coater.jpg
- 800×800
- 2015/10/20 04:20
- 41.9 KB

- yamamotoconvectionoven.png
- 974×1254
- 2022/05/27 22:32
- 722.3 KB
- yamamotodkn602c_oven.pdf
- 2022/05/27 22:42
- 1.5 MB

- zeissinvmicroscope.jpg
- 640×640
- 2021/07/23 19:15
- 30.5 KB
- zen_2_blue_edition_-_software_guide.pdf
- 2021/07/23 19:35
- 8.6 MB
File
lims-guide-viewing-data.txt · Last modified: by csdunham


